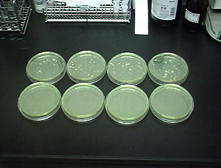

侾丏栚丂揑
丂惷壀導撪偺儅僗僋儊儘儞嵧攟尰応偱偼Agrobacterium rhizogenes乮傾僌儘僶僋僥儕僂儉丒儕僝僎僱僗乯偵傛傞偲尒傜傟傞栄崻昦偑枹偩愨偊偢丄
彮側偐傜偢傕儊儘儞嵧攟擾壠偵懪寕傪梌偊偰偄傞丅
丂栄崻昦偼A. rhizogenes biovar-1偺姶愼偵傛偭偰堷偒婲偙偝傟傞傕偺偱丄滊昦偟偨儊儘儞偼栄崻偑嵧攟搚昞柺偵枾惗偟丄杮棃偺崻
偺摥偒偑慾奞偝傟傞偨傔偵悈娗棟偑崲擄偲側傞丅偙偺偨傔丄壥幚偺曄宍傗摐搙偺掅壓丄僱僢僩偺棎傟側偳傪惗偠丄彜昳壙抣傪挊偟偔懝側偆寢壥偲側傞丅
丂嵧攟尰応偵偍偗傞栄崻昦懳嶔偲偟偰偼丄嘆嵧攟搚忞偺嶦嬠丄嘇旝惗暔帒嵽偺搳擖丄嘊嵧攟彴偲偟偰巊梡丄嘋嵧攟丄偺僒僀僋儖偑幚巤偝傟偰
偄傞偑丄撍敪揑側栄崻昦偺敪惗偑偟偽偟偽孞傝曉偝傟丄傛傝岠壥揑側懳嶔曽朄偺奐敪偑懸偨傟偰偄傞丅
丂杮婇夋偼丄栄崻昦偵桳岠偲尒傜傟傞旝惗暔宯搚忞夵椙嵻偵拝栚偟丄偙傟傜偺桳岠惈妋擣専摙傪幚巤偡傞夁掱偱摼傜傟傞栤戣揰傗壽戣傪嵞惍
棟偟丄怴偨側儊儘儞栄崻昦懳嶔曽朄傪棫埬偡傞偙偲傪栚揑偲偡傞丅
俀丏嵽椏偲曽朄
乮侾乯懳徾帒嵽
丂懳嶔懳徾帒嵽偼俶幮惢偺亂帒嵽俙亃偲亂帒嵽俛亃傪梡偄偨丅亂帒嵽俙亃偼姰弉懲旍偱偁傝丄亂帒嵽俛亃偼亂帒嵽俙亃傪曗嫮偡傞偨傔偺旝惗暔帒嵽偱偁傞丅
乮俀乯懳徾搚忞
丂栄崻昦偵滊昦偟偨搚忞偼丄惷壀導撪偺儊儘儞嵧攟擾壠乮俲巵乯傛傝忳傝庴偗偨傕偺傪巊梡偟偨丅
乮俁乯栄崻昦嵶嬠偺専弌曽朄
丂栄崻昦嬠偺暘棧攟梴偼丄Schroth et al.偺慖戰攟抧傪儀乕僗偵専摙偟偨丅専摙寢壥偺奣梫偼埲壓偺捠傝偱偁傞丅
丂嘆丂挷惢偵娭偟偰
丂Schroth et al.暲傃偵杚栰岶岹乮1993乯偵傛傞夵曄慻惉偱偼攟抧偺挷惢拞偵捑揳傪惗偠丄忢朄偱偺埖偄偼崲擄側傕偺偲峫偊傜傟偨丅偙偺偨傔丄捑揳傪
惗偠傞帋栻偵偮偄偰専摙偟丄儕儞巁儅僌僱僔僂儉傪僌儕僙儘儕儞巁偵曄峏偟丄扽巁儅僌僱僔僂儉偺揧壛傪僛儘偲偟偨丅偙偺寢壥丄攟抧偼栤戣側偔挷惢壜
擻偲側偭偨丅儅僌僱僔僂儉偼墫壔儅僌僱僔僂儉偱廩暘梌偊傜傟偰偍傝丄栚揑偲偡傞嵶嬠偺憹怋偵偼塭嬁偼柍偄傕偺偲峫偊偨丅
丂嘇丂嵶嬠偺憹怋偵娭偟偰
丂扽慺尮傪儅儞僯僩乕儖偲偟偨応崌丄夵曄Schroth et al.慖戰攟抧忋偱偺僐儘僯乕偺敪払偼憗偔丄傑偨懡偔偺僐儘僯乕傪宍惉偟偨乮俲巵搚忞偱800亊104屄/g乯丅
堦曽丄扽慺尮傪僟儖僔僩乕儖偲偟偨応崌丄僐儘僯乕偵敪払偼抶偔丄僐儘僯乕悢偼1/10掱搙偵尭彮偟偨丅杚栰岶岹乮1993乯偵傛傟偽丄扽慺尮傪儅儞僯僩乕儖
偲偟偨攟抧忋偱偼嶨嬠偑懡偔憹怋偡傞偲偝傟偰偍傝丄扽慺尮偼僟儖僔僩乕儖傪巊傢偞傞傪摼側偄丅扐偟丄僟儖僔僩乕儖偼崅壙側栻嵻偱偁傞懠丄崙撪偱偼惢
憿偝傟偰偄側偄偙偲偐傜擖庤偵偼帪娫偲僐僗僩偑偐偐傞擄揰偑偁傞丅
乮係乯帋椏挷惢偺曽朄
丂杚栰岶岹乮1993乯偵傛傟偽丄儊儘儞栄崻昦嬠偼俁亾NaCl偵懴惈傪桳偡傞偲偝傟偰偄傞丅偦偙偱丄嵟弶偺抜奒偱専懱搚忞傪俁亾NaCl塼偵寽戺偝偣傞偙偲偱
嶨嬠傪偁傞掱搙攔彍壜擻偲峫偊偨丅庬乆偺帋峴帋尡偺寢壥丄栄崻昦嬠専弌偵揔偟偨搚忞帋椏偺挷惢曽朄傪埲壓偺傛偆偵寛掕偟偨丅
丂嘆丂嵶嬠孮偺嵦庢
丂幖揇侾倗傪攭検偟丄100mL柵嬠價乕僇乕偵嵦傞丅偙傟偵柵嬠俁亾NaCl塼100mL傪擖傟偰奾漚偟丄挻壒攇愻忩婡偵俆暘偐偗傞丅惷抲20昩屻偺忋悷傒10mL傪
柵嬠帋尡娗偵嵦傝丄800rpm俆暘墦怱偡傞丅忋悷傒慡検傪愙庬尨塼偲偡傞丅
丂嘇丂愙庬尨塼偺婓庍抜奒
丂扽慺尮偵儅儞僯僩乕儖傪梡偄偨応崌偼愙庬塼偼尨塼偺1/100偑丄傑偨丄僟儖僔僩乕儖傪梡偄偨応崌偼1/10偑揔摉偱偁傞丅
丂嘊丂嵶嬠孮偺愛庢偲攟梴
丂夵曄Schroth et al.慖戰攟抧僔儍乕儗乕忋偵愙庬塼100兪L傪揾枙愙庬偡傞丅25亷,俉乣10擔娫攟梴偟丄僐儘僯乕傪寁悢偡傞丅
乮俆乯姶愼搚忞傊偺崿擖帋尡偺曽朄
丂栄崻昦嬠専弌妋擣帋尡偵傛偭偰姶愼偑妋擣偝傟偨俲巵搚忞傪梡偄偰崿擖帋尡傪幚巤偟偨丅帋尡偼侾帋尡摉偨傝侾L偺搚忞傪梡偄丄埲壓偺帋尡嬫傪愝掕偟偰
幚巤偟偨丅
丂嘆懳丂徠丂嬫丒丒丒丒丒丒丒丒丒丒丒丒姶愼搚忞
丂嘇亂帒嵽俙亃揧壛嬫丒丒丒丒丒丒丒姶愼搚忞亄亂帒嵽俙亃乮10亾乯
丂嘊亂帒嵽俛亃俆亾揧壛嬫丒丒丒丒 姶愼搚忞亄亂帒嵽俛亃乮俆亾乯
丂嘋亂帒嵽俛亃10亾揧壛嬫丒丒丒丒 姶愼搚忞亄亂帒嵽俛亃乮10亾乯
丂帋尡壏搙偼25亷堦掕丄岝偼敀怓寀岝摂2,000Lux楢懕忦審偱偁傞丅



幨恀俀亅侾丂嵍丗帒嵽宍懺乮帒嵽俙,帒嵽俛乯丂拞丗帋椏張棟丂塃丗崿擖帋尡忬嫷



幨恀俀亅俀丂嵍丗僐儘僯乕僇僂儞僩丂拞丗崿擖帋尡侾廡娫屻偲俁廡娫屻偺宍惉僐儘僯乕丂塃丗暘棧僐儘僯乕
俁丏寢丂壥
丂帋尡寢壥傪昞俁亅侾暲傃偵恾俁亅侾偵帵偟偨丅
丂帋尡奐巒俈擔偱偼奺帋尡嬫嫟偵戝偒偔曄傢傜側偄偐庒偟偔偼嘋亂帒嵽俛亃10亾揧壛嬫偱憹壛偟偰偄傞傛偆偵傕尒偊傞偑丄21擔乮俁廡娫乯偱偼嘊丄嘋帋尡嬫
偱尭彮偑尒傜傟偰偄傞丅
丂寢榑偲偟偰丄亂帒嵽俛亃傪俆亾埲忋崿擖偡傞偙偲偱儊儘儞栄崻昦偼梷惂偺壜擻惈戝偲敾抐偝傟偨丅
昞俁亅侾栄崻昦嵶嬠孮悢偺宱帪曄摦丂丂丂丂丂乮亊10,000屄/g乯

丂仸帋尡嬫偺斣崋偼俀偺乮俆乯偵懳墳

恾俁亅侾栄崻昦嵶嬠孮悢偺宱帪曄摦
係丏尰抧帋尡偺宱夁
乮侾乯巤梡曽朄偺専摙
丂幒撪帋尡偵傛偭偰亂帒嵽俛亃偑儊儘儞栄崻昦傪梷惂偱偒傞壜擻惈偑崅傑偭偨偨傔丄幚嵺偺嵧攟尰応偱偺巤梡帋尡傪帋傒偨丅
丂亂帒嵽俛亃傪嵧攟搚忞慡懱偵懳偟偰俆亾埲忋壛偊傞偙偲偼宱嵪揑偱側偄偨傔丄儊儘儞掕怉帪偺崻堟暲傃偵掕怉慜偺堢昪婜偵巤梡偡傞曽岦偱専摙偟偨丅
丂嘆掕怉帪偺捈愙巤梡
丂丂掕怉帪偺怉偊寠偵50g偲100g傪搳擖偟丄崻從偗偵傛傞怉奞偺桳柍偲栄崻昦梷惂岠壥傪専徹偟偨丅
丂嘇堢昪梡搚偵10亾傪壛偊丄掕怉屻偺栄崻昦梷惂岠壥傪専徹偟偨丅
乮俀乯巤梡寢壥
丂亂帒嵽俛亃偼崻堟偵捈愙搳擖偟偰傕儊儘儞偺堢昪偵壗傜栤戣偼惗偠側偐偭偨丅傑偨丄偙偺帋尡昪偼廃曈昪偑栄崻昦偵滊昦偟偨偵傕偐偐傢傜偢丄廂妌傑偱偺
娫滊昦偟側偐偭偨丅
丂堢昪梡搚偵10亾傪壛偊偨帋尡偱偼偡傋偰偑弴挷偵惗堢偟丄俉妱偑滊昦偟側偐偭偨丅巆傝俀妱偼寉偄栄崻昦偺徢忬傪帵偟偨偑丄廂妌暔偵偼壗傜栤戣偼柍偐偭偨丅
丂摨偠壏幒撪偱亂帒嵽俛亃傪巤梡偟側偐偭偨儊儘儞昪偼廬棃捠傝偺枬惈揑側栄崻昦偺徢忬傪帵偟丄侾妱偼廂妌晄壜擻偱偁偭偨丅埲忋偺寢壥偐傜丄亂帒嵽俛亃偼
栄崻昦偺梷惂偵戝偒側岠壥偑偁傞偲寢榑偝傟偨丅
乮俁乯偦偺屻偺宱夁
丂帋尡擾壠偱偼偦偺屻丄亂帒嵽俛亃傪惓幃摫擖偟丄堢昪梡搚傊偺10亾崿擖偲掕怉帪偺捈愙巤梡傪暪梡偟偰椙偄惉壥傪廂傔偰偄傞丅
丂仸丂尰抧帋尡偺徻嵶乮幨恀摍乯偼尰嵼偺偲偙傠峊偊偝偣偰捀偄偰偍傝傑偡丅岞奐壜擻偲側傝傑偟偨傜堷偒懕偒宖嵹偟偰偄偔梊掕偱偡丅
亂偍栤崌偣亃
 |
偍栤崌偣儁乕僕傊 |
丂 |
|
|
|